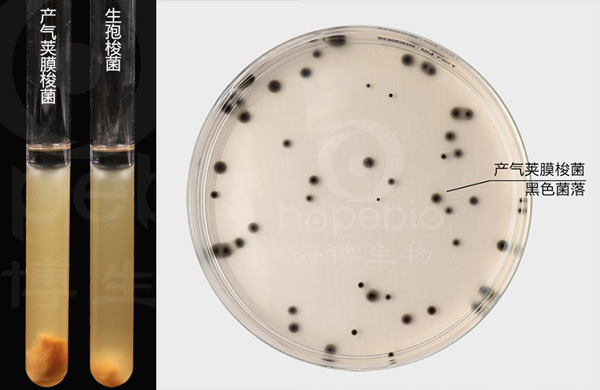
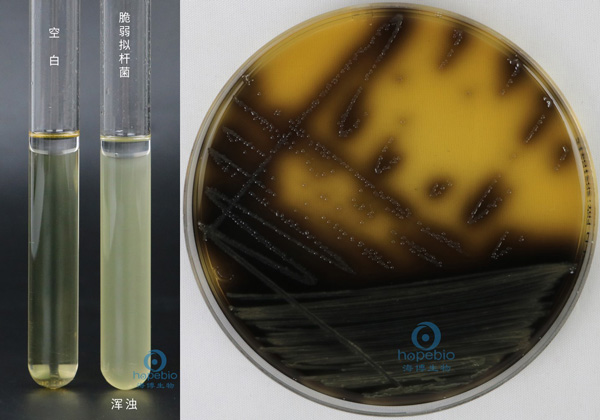
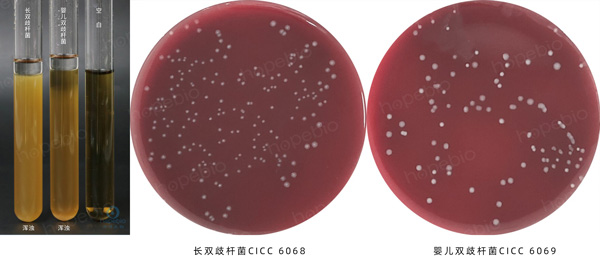

海博微信公众号
海博微信公众号
 海博天猫旗舰店
海博天猫旗舰店


 海博微信公众号
海博微信公众号
 海博天猫旗舰店
海博天猫旗舰店




在地球无氧或低氧的隐秘角落,厌氧微生物构建起独特的生命体系。它们无需氧气即可繁衍,涵盖细菌、古菌、真菌等多个类群,其特殊的代谢机制和生态功能,使其在生态循环与人类生产生活中占据重要地位。它们广泛分布于自然界和人及动物的体内,特别是在肠道、口腔、上呼吸道和泌尿道等处,与需氧菌和兼性厌氧菌共同构成机体的正常菌群。
一、专性厌氧菌——极致厌氧环境的适应者
专性厌氧菌无法耐受氧气,其细胞内缺乏超氧化物歧化酶、过氧化氢酶等抗氧化酶系,暴露在有氧环境中会因活性氧积累导致细胞损伤死亡。
1、梭菌属
广泛存在于土壤、淡水沉积物、动物肠道及腐烂的有机物中,是自然界有机物分解的重要参与者。
梭菌属为革兰氏阳性杆菌,多数菌株能形成圆形或椭圆形芽孢,芽孢直径常大于菌体宽度,使菌体呈“鼓槌状”(如破伤风梭菌)或“网球拍状”(如肉毒梭菌),芽孢具有极强的抗逆性,可在土壤中存活数十年。为严格发酵代谢,能利用葡萄糖、淀粉等多种碳水化合物,产生有机酸、醇类、气体(氢气、二氧化碳)等产物。丙酮丁醇梭菌发酵过程分为两个阶段,第一阶段产酸(乙酸、丁酸),第二阶段产溶剂(丙酮、丁醇、乙醇),溶剂产量可达发酵液的10%-15%。
典型菌株主要有破伤风梭菌,为致病性菌种,通过伤口侵入人体,产生破伤风痉挛毒素,引发肌肉强直;肉毒梭菌产生肉毒毒素(已知毒性最强的神经毒素),常见于变质罐头、发酵食品中;丙酮丁醇梭菌,工业价值极高,可发酵淀粉产生丙酮、丁醇等有机溶剂。
除庖肉培养基外,还可使用强化梭菌培养基进行培养,培养温度为25℃-37℃,氧气浓度需低于0.5%。
图1 梭菌在庖肉培养基及强化梭菌鉴别琼脂上的生长现象
2、拟杆菌属
主要定植于人和动物的肠道、口腔、阴道等黏膜表面,其中脆弱拟杆菌是人体结肠中数量最多的细菌之一,占肠道厌氧菌总量的20%-30%。
拟杆菌属为革兰氏阴性杆菌,无芽孢、无鞭毛,部分菌株可产生荚膜,菌落呈圆形、光滑、边缘整齐,颜色从乳白色至淡黄色。为专性发酵,能分解膳食纤维(如纤维素、半纤维素、果胶)、黏蛋白等难消化有机物,产生乙酸、丙酸、丁酸等短链脂肪酸(SCFAs),这些产物可被人体肠道上皮细胞吸收利用,提供每日所需能量的10%-15%。
典型菌种为脆弱拟杆菌,能分解膳食纤维生成短链脂肪酸,为人体供能,同时调节肠道免疫。可用于分离、培养脆弱拟杆菌主要有脆弱拟杆菌活化培养基肉汤(BPRMB)及类杆菌-胆汁-七叶苷琼脂(BBE)。
图2 脆弱拟杆菌在BPRMB和BBE培养基上的生长现象
3、双歧杆菌属
主要存在于婴儿肠道中(占婴儿肠道菌群的60%-80%),成人肠道中含量虽减少,但仍是核心有益菌之一,也存在于母乳、动物肠道及发酵食品中。
双歧杆菌属为革兰氏阳性杆菌,形态多样,包括杆状、分叉状、弯曲状等,大小约0.5 μm-1.3 μm×1.5 μm-8.0 μm,无芽孢、无鞭毛,菌落呈圆形、凸起、光滑,颜色为乳白色或奶油色。独特的“双歧发酵”途径,将葡萄糖分解为乙酸和乳酸,比例约为3:2,不产生氢气,发酵产物可降低肠道pH值,抑制有害菌(如大肠埃希氏菌、沙门氏菌)生长。此外,还能合成维生素B族、叶酸等营养物质,并产生抗菌肽(双歧杆菌素)。
典型菌种包括婴儿双歧杆菌和长双歧杆菌等,可抑制有害菌增殖,改善肠道微生态平衡。增菌、分离培养双歧杆菌的培养基主要有PYG液体培养基、BLB琼脂等。
图3 双歧杆菌在PYG液体培养基、BLB琼脂上的生长现象
4、产甲烷古菌
主要存在于沼泽、稻田、湿地、动物瘤胃、肠道及污水处理厂的厌氧消化池中,是全球甲烷排放的主要贡献者。
产甲烷古菌形态多样,包括球形、杆状、螺旋状等,大小约0.5 μm-1.5 μm,细胞壁不含肽聚糖,由假肽聚糖或蛋白质构成,细胞膜脂质为独特的植烷醇甘油醚,而非脂肪酸甘油酯。唯一能以甲烷为终产物的微生物,代谢途径分为三类,嗜乙酸型(利用乙酸生成甲烷和二氧化碳)、嗜氢型(利用氢气和二氧化碳生成甲烷)、甲基营养型(利用甲醇、甲胺等生成甲烷)。产甲烷过程需多种辅酶(如辅酶M、辅酶F420)参与,其中辅酶F420具有荧光特性,可作为产甲烷菌的鉴定标志。
典型菌种有嗜乙酸甲烷八叠球菌、嗜氢甲烷杆菌等,培养需严格无氧。
二、兼性厌氧菌——有氧与无氧环境的“切换者”
兼性厌氧菌可以在有氧环境中利用氧气进行有氧呼吸,在无氧环境下则进行发酵或无氧呼吸,适应能力极强。
1、大肠埃希氏菌
主要定植于人和温血动物的大肠中,也存在于土壤、水源、食品等环境中,多数菌株为无害共生菌,少数致病性菌株(如O157:H7)可引发腹泻、出血性肠炎等疾病。
革兰氏阴性短杆菌,有鞭毛(多数菌株),能运动,无芽孢,菌落呈圆形、光滑、湿润,颜色为乳白色。有氧时进行有氧呼吸,以氧气为电子受体;无氧时发酵葡萄糖产生乳酸、乙酸、琥珀酸、乙醇及气体(氢气、二氧化碳),部分菌株还能利用硝酸盐作为电子受体进行无氧呼吸(硝酸盐还原)。
普通营养琼脂即可生长,培养温度37℃,有氧或无氧环境均可,厌氧条件下可使用硫乙醇酸盐培养基,发酵乳糖产酸,在伊红美蓝琼脂(EMB)上形成紫黑色带金属光泽的菌落。
2、酿酒酵母
广泛存在于水果表皮、花蜜、土壤及发酵食品(酒、面包、酸奶)中,是人类最早驯化利用的微生物之一。
酿酒酵母为真核微生物,圆形或椭圆形酵母菌,出芽生殖为主要繁殖方式,菌落呈圆形、凸起、光滑,颜色为乳白色至淡黄色,质地柔软。无氧时发酵葡萄糖产生乙醇,有氧时进行有氧呼吸,产生二氧化碳和水,同时大量增殖。
常用麦芽浸粉液体培养基和酵母浸出粉胨葡萄糖琼脂培养基(YPD)等培养酿酒酵母,有氧培养时需振荡供氧,厌氧培养时密封发酵。
三、微需氧菌——低氧环境的“特殊需求者”
微需氧菌需要极低浓度的氧气(1%-5%)作为代谢电子受体,氧气浓度过高(>10%)或无氧环境均会抑制其生长,细胞内含有少量抗氧化酶系,能耐受低浓度活性氧。
1、幽门螺杆菌
专门定植于人类胃黏膜上皮细胞表面,是慢性胃炎、消化性溃疡、胃癌的重要致病菌。
为革兰氏阴性螺旋形杆菌,有鞭毛(一端或两端),能运动,可穿透胃黏膜表面的黏液层,菌落呈圆形、透明或半透明,边缘整齐。微需氧代谢,能产生脲酶(活性极强),分解尿素产生氨,中和胃内胃酸,形成局部碱性微环境,以适应胃内酸性环境(pH值1-3)。同时能发酵葡萄糖、麦芽糖等,产生乙酸、乳酸等产物。
2、空肠弯曲菌
主要存在于鸡、鸭、猪等家禽家畜的肠道中,可通过污染的肉类、蛋类、水源传播给人类,引发急性肠炎,症状包括腹泻、腹痛、发热等。
为革兰氏阴性弯曲形杆菌,有单鞭毛(一端),运动活泼,呈“螺旋式”运动,菌落呈圆形、光滑、湿润,颜色为灰白色或粉红色。微需氧发酵,能利用葡萄糖、果糖等碳水化合物,产生乙酸、丙酮酸等产物,不发酵乳糖,能还原硝酸盐为亚硝酸盐。
空肠弯曲菌主要用布氏肉汤和改良Skirrow氏琼脂基础等培养基进行增菌、分离培养等。

图4 空肠弯曲菌在改良Skirrow氏琼脂上的生长现象
四、相关产品
部分可用于培养厌氧微生物的培养基:
|
产品货号 |
产品名称 |
用途 |
|
HB0259 |
用于厌氧菌的增菌培养 |
|
|
HB0285 |
用于食品和其它物质中梭菌的培养和计数 |
|
|
HB8721 |
用于脆弱拟杆菌活化培养 |
|
|
HB7028 |
用于脆弱拟杆菌群的分离培养 |
|
|
HB0398 |
用于双歧杆菌的增菌培养 |
|
|
HB7034 |
用于双歧杆菌的分离培养 |
注:本文属海博生物原创,未经允许不得转载。
上一篇:厌氧菌常用液体培养基及使用方法
| 相关文章: | ||



